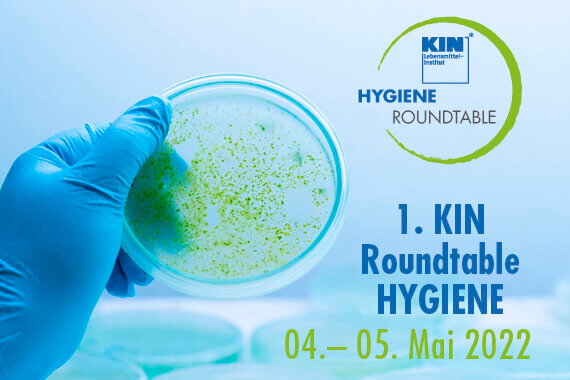

Nach der langen mittlerweile 2-jährigen pandemiebedingten Durststrecke war es endlich wieder so weit: Am Donnerstag, den 28.04.2022 fuhren 89 Schüler und Schülerinnen mit Fachlehrern der KIN Fachschule für Lebensmitteltechnik zur...

Alle Neuigkeiten und Termine nach Kategorien:

Kostenloses WHITEPAPER zur Validierung thermischer Lebensmittel-Haltbarmachungsprozesse
VALIDIERUNGEN MIT DEM KIN – EFFEKTIV UND EFFIZIENT Prozessvalidierungen sind sowohl vom Gesetzgeber vorgeschrieben als auch vom Handel gefordert. Das KIN ist für das Verfahren der Prozessvalidierung akkreditiert, sodass Unternehmen,...

SH Wirtschaftsminister Dr. Buchholz im Gespräch mit KIN Institutsleiter Wiechmann – Podcast Echte Chancen
Unser Institutsleiter und Geschäftsführer Christian Wiechmann war im #EchteChancen-Podcast zu Gast. Mit Wirtschaftsminister Dr. Bernd Buchholz spricht er über Produktqualität und Lebensmittelsicherheit, die Bedeutung der Fachkräfteentwicklung in SH und die...

KIN-Campus-Day. Create your career – Karriere beginnt am KIN!
Am 03. Juni 2022 ab 11:00 Uhr laden wir Sie herzlich zum KIN-Campus-Day in Neumünster ein, denn beruflicher Erfolg ist kein Zufall, sondern Ergebnis von aktuellem Fachwissen, praktischen Erfahrungen und...

Absolventen der KIN-Fachschule – begehrte Lebensmittel-Fachkräfte im In- und Ausland dank modernster Lernmethoden
Unter Anwesenheit von Landtagsvizepräsidentin Frau Kirsten Eickhoff-Weber und Institutsleiter Christian Wiechmann haben am 31. März, 20 frisch examinierte, staatlich geprüfte Lebensmitteltechniker/innen sichtbar glücklich Ihre Zeugnisse aus den Händen des Schulleiters...

Erfolgreiche Weiterbildung zum Prozessmanager thermische Haltbarmachung
Ende März war es wieder so weit, die KIN Spring School fand in einer Neu-Auflage statt. In dem 4-tägigen Intensiv-Workshop erwarben die Teilnehmer profunde Kenntnisse und Fähigkeiten im Bereich thermische...

Ghanaische Delegation besucht das KIN-Lebensmittelinstitut
Im Rahmen eines Managerfortbildungsprogramms „Food Processing & Cosmetics“, welches durch Invest for Jobs und die deutsche Gesellschaft für Internationale Zusammenarbeit (GIZ) unterstützt wird, besuchte eine Ghanaische Delegation das KIN. Am...

Aus aktuellem Anlass: „Worst Case“ Warenrückruf oder gar Produktionsstättenschließung
Dass der aktuelle „Worst Case“ von Salmonellen in Schokoladenprodukten kein Einzelfall ist, zeigt ein Blick in die jüngsten Meldungen des BVL Portals: Dort reihen sich die Warnungen vor dem Verzehr...

Neues aus der Presse – PET
KIN baut Angebot für Petfood-Firmen aus “Ob es sich um die Qualifizierung von Fachpersonal handelt oder um die Entwicklung bzw. Validierung sicherer Produktionsprozesse: Das KIN-Lebensmittelinstitut in Neumünster ist für Unternehmen...
1. KIN Roundtable – Hygiene – ab sofort Anmeldung möglich
Jetzt Teilnahme sichern am 1. KIN Roundtable Hygiene! Am 4./5. Mai 2022 im KIN Lebensmittelinstitut in Neumünster – anlässlich des Welt-Hand-Hygienetages 2022 – lautet das Motto Zeit für Sauberkeit! Mit...

Wieder ein erfolgreiches Audit in der KIN Fachschule für Lebensmitteltechnik
Mit dem erfolgreichen Bestehen des Audits am 21.02.2022 wurde die Wirksamkeit des eingeführten Qualitätsmanagementsystems (DIN EN ISO 9001:2015) und die Einhaltung der Anforderungen im Bereich AZAV durch die Auditorin erneut...

Die Lebensmittelindustrie verstehen… als Food Business Manager
Sie sind im Unternehmen gefordert, kreative und innovative Ideen in haltbare, sichere und gewinnbringende Produkte umzusetzen? Als Quereinsteiger in einem Unternehmen der Lebensmittel-, Verpackungs- oder Tiernahrungs-Branche sind Sie gerade dabei,...



